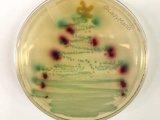

В Сети показали самые странные новогодние елки (фото)
25.12.2018 18:52
Эти новогодние деревья определенно не похожи на традиционные и отличаются креативностью.

Слон втік із цирку і ходив вулицями міста в США (відео)
Слон втік із цирку і ходив вулицями міста в США (відео)
 Повне сонячне затемнення в США: NASA веде пряму трансляцію (відео)
Повне сонячне затемнення в США: NASA веде пряму трансляцію (відео)
 Звіти по зборам, Грянстер, РЕР-анті фпв,возики,двигуни вже на фронті та ін. Збір 7 квітня 25 млн грн
Звіти по зборам, Грянстер, РЕР-анті фпв,возики,двигуни вже на фронті та ін. Збір 7 квітня 25 млн грн
 Повістка як помста. СБУ стежила за журналістом «Слідства.Інфо» через розслідування
Повістка як помста. СБУ стежила за журналістом «Слідства.Інфо» через розслідування
 Микола Давидюк про політиків з ТікТоку, тренд на виживання і як нетоксично відмовляти клієнтам
Микола Давидюк про політиків з ТікТоку, тренд на виживання і як нетоксично відмовляти клієнтам
 MOLODI — живу наполовину (official video)
MOLODI — живу наполовину (official video)
 Вибори Президента. Заміна Залужного. День 710-й
Вибори Президента. Заміна Залужного. День 710-й
 Алкоголь – від стресу. Чому це не допоможе? Пояснює психолог
Алкоголь – від стресу. Чому це не допоможе? Пояснює психолог



















